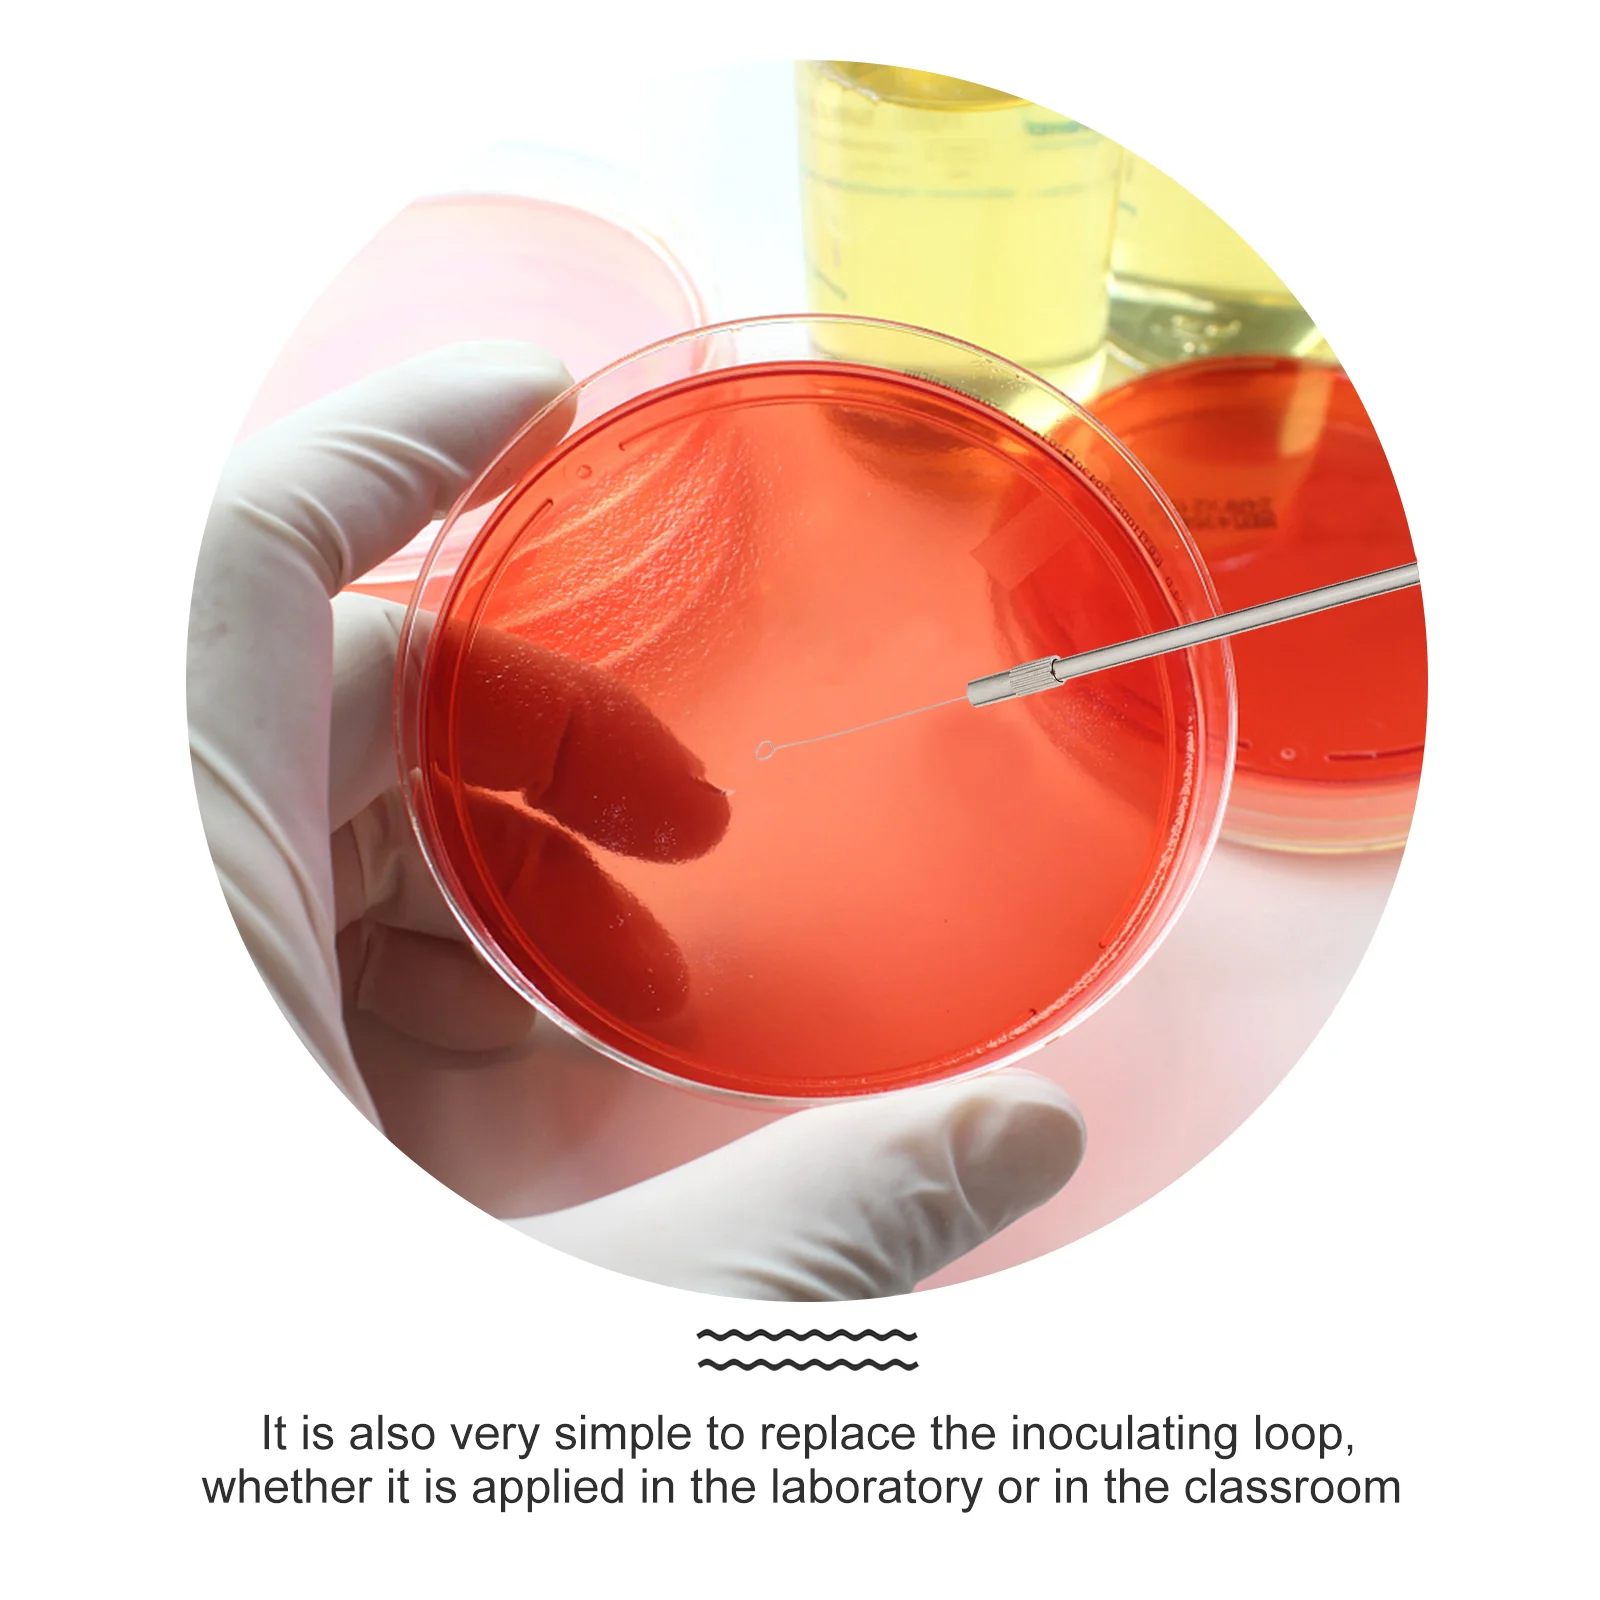

Инструмент для микробиологии, инструмент для инокуляции, проволочный лабораторный стержень
Price history chart & currency exchange rate
Customers also viewed

$3.44
3pcs Silicone Cake Molds for Baking 8 Inch Non Stick Food Grade Safe Round Bakeware Pan Mold Party
aliexpress.ru
$92.41
Uav 900MHZ Power Amplifier Module 10W Power Inverse Image Transmission Positioning FPV Crossing Machine
aliexpress.com
$35.77
Integrated Top Quality Sheep Horn Hammer Woodworking Site Household Shockproof Multifunctional Connected Hammer with Magnetic
aliexpress.com
$7.69
Woman Belly Dancing Hat Handmake Bead Dancing Hat 3colors Woman Belly Tassel Hat Accessories
aliexpress.com
$2.60
Universal Drop Leg Gun Holster Right Handed Tacticals Thigh Pistol Bag Pouch Legs Harness Adjustable For All Handguns
aliexpress.com
$312.35
Новый мощный электрический коммерческий Погружной блендер, ручной блендер по заводской цене
aliexpress.ru
$28.01
Women Party Dress Asymmetric Falbala Black Orange Midi Robe Femme Vestiods Autumn Office Lady Workwear Elegant African Dresses
aliexpress.com
$1.75
Cartoon Mini TAYO Bus Taxi Back Children Educational Toys Little Bus Korean Anime Model Buses for Kids Birthday Gifts 4pcs/set
aliexpress.com
$0.86
Women Travel Cosmetic Bag Casual Zipper Make Up Transparent Makeup Case Organizer Storage Pouch Toiletry Beauty Wash Kit Bags
aliexpress.com
$10.68
Spaceship 3D Lamp LED 7 Colors Decorative Night Light USB Touch Table Lamp Space Warship Atmosphere Light Christmas Gifts
aliexpress.com
$33.53
mens hoodies sweatshirts mens hoodies sweatshirts foam print sp5der 555555 hoodies sweatshirt set oversized men women spider web young thug, Black
dhgate.com
$67.77
2021 new car styling car portable folding umbrella sunshade for e46 e39 e38 e90 e60 e36 x5 x3 x6 with m/performance logo
fordeal.com
$80.31
Сетчатая Центральная решетка, 1 шт., модифицированные детали в европейском стиле, автозапчасти, подходит для Audi 2008-13 A3
aliexpress.ru
$29.51
100 шт./компл. деревянный кубический кирпич, игра, кубики 2,5 см, Набор цветных блоков «сделай сам», игрушки, деревянные обучающие игрушки для ма...
aliexpress.ru
$3.88
New Original Xiaomi Redmi Buds 3 Lite Earbuds TWS Ture Wireless Headphones with Mic Fone Bluetooth Headphones Buds 3 Headset
aliexpress.ru
$9.07
Customize Birthday Party Backdrop Wall Decor Poster Banner Black Sliver Photo Background for Girl Women 11th 13th 16th 18th 21th
aliexpress.com
$12.25
Стайлинг автомобиля, внутренний светильник для чтения, внутренний потолочный светильник, купольный светильник для Nissan Paladin NV200
aliexpress.ru
$27.57
Умная бесконтактная мусорная корзина, 3 галлона, автоматический датчик движения, мусорная корзина с крышкой, электрическая Водонепроницаем...
aliexpress.ru
$10.78
Диспенсер для воды, электрический насос с USB-зарядкой, автоматический переключатель
aliexpress.ru
$69.55
Светодиодный контроллер Artnet, контроллер DMX Artnet WS2801 WS2811, яркий светодиодный пиксельный контроллер для Гирлянд
aliexpress.ru
$10.52
Набор швейных ниток 60 шт./компл. набор швейных ниток смешанных цветов включает катушки ниток металлические шпули с нитями Швейные аксессуар...
aliexpress.ru
$86.30
thick-soled canvas shoes breathable all-match casual women's shoes sneakers high-rise sneakers
fordeal.com
$67.63
bag women's bag 2021 new simple fashion retro letter printing single shoulder messenger chain bag bags small square bagtote bag ins
fordeal.com
$37.44
совет шорты мужчины стильные printed отдыха плюс размер 4xl сыпучие chic тонкий мужские купальник быстрый сушки дышащий все матча пляжная, White;black
dhgate.com
$83.94
UNI-T Professional UTG932E Waveform Generator 30MHz DDS Dual Channel Signal Generator Counter 200MSa/s 14bits Frequency Meter
aliexpress.com
$5.75
Celebrity Charlize Theron Actresses South Africa HD Wall Poster Fine Art Print(12 inch X 18 inch, Rolled)
flipkart.com
$6.47
Akhuratha Michael Jackson Fine Quality Wall Poster Paper Print(12 inch X 8 inch, Rolled)
flipkart.com